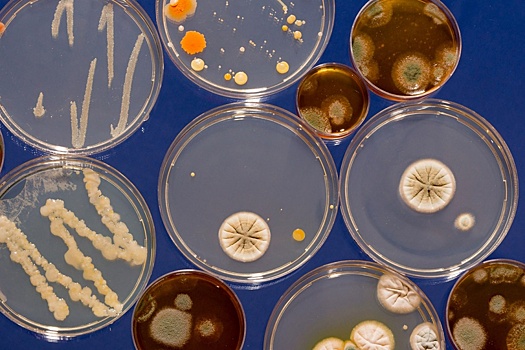
Дома Немецкого рынка в Москве получили охранный статус
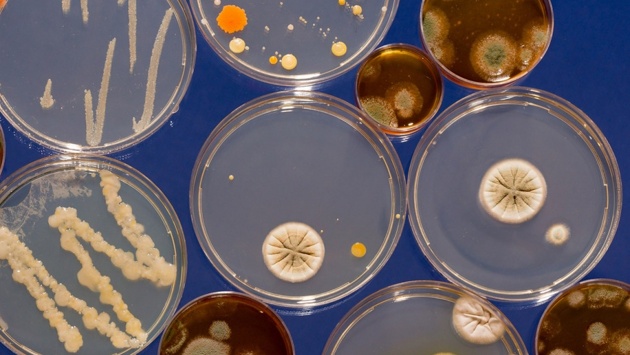

Дома Немецкого рынка в Москве получили охранный статус
Купеческие малоэтажные дома Немецкого рынка в Москве внесли в список выявленных объектов культурного наследия, сообщается на сайте столичной мэрии.
Как указывается в сообщении, расположенный на улице Фридриха Энгельса архитектурный ансамбль в стиле классицизма — образец типичной торговой застройки позапрошлого столетия. Здания располагаются в историческом районе Немецкой слободы, почти полностью уничтоженном при пожаре 1812 года. Его восстановили к середине XIX века и заселили столичные купцы и мещане.
"Каждое строение — это прекрасный пример малоэтажного купеческого дома XIX века с торговыми помещениями на первом этаже и жилыми — на втором. Ансамбль зданий полностью отражает облик всей Немецкой слободы. При этом они практически полностью сохранили свой исторический вид", — приводятся в сообщении слова главы Мосгорнаследия Алексея Емельянова.
Самое раннее из включенных в список зданий построено в 1825 году, добавляется в сообщении.
Немецкая слобода образовалась на правом берегу Яузы в 1652 году. По указу царя Алексея Михайловича здесь должны были селиться все иностранцы, не принявшие православие.